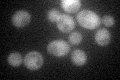
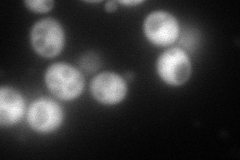
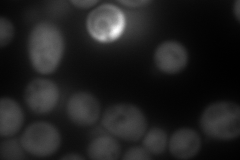
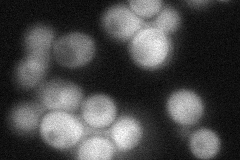
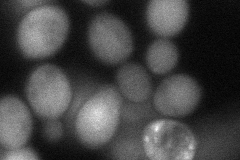
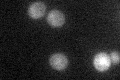

View description
Ubiquitin-like protein with weak sequence similarity to ubiquitin; depends on the E1-like activating enzyme Uba4p; molecular function of the Urm1p pathway is unknown, but it is required for normal growth, particularly at high temperature
Localization:
Intensity:
Fold change:
Significance:
-
C’ GFP library in SD
cytosol39.69 -
N' NOP1pr-GFP in SD
cytosol230.928 -
N' TEF2pr-mCherry in SD
cytosol386.696 -
N' NATIVEpr-GFP in SD
cytosol51.0719 -
N' TEF2pr-VC and Cyto-VN in SD
cytosol61.411 -
C’ GFP library in SD+DTT

cytosol30.710.77No -
C’ GFP library in SD+H2O2

cytosol40.561.02No -
C’ GFP library in Starvation Media
cytosol31.320.78No -
C’ GFP library on the background of Pup2-DaMP

cytosol -
C’ GFP library on the background of CCT mutant

cytosol34.87880.878567No
